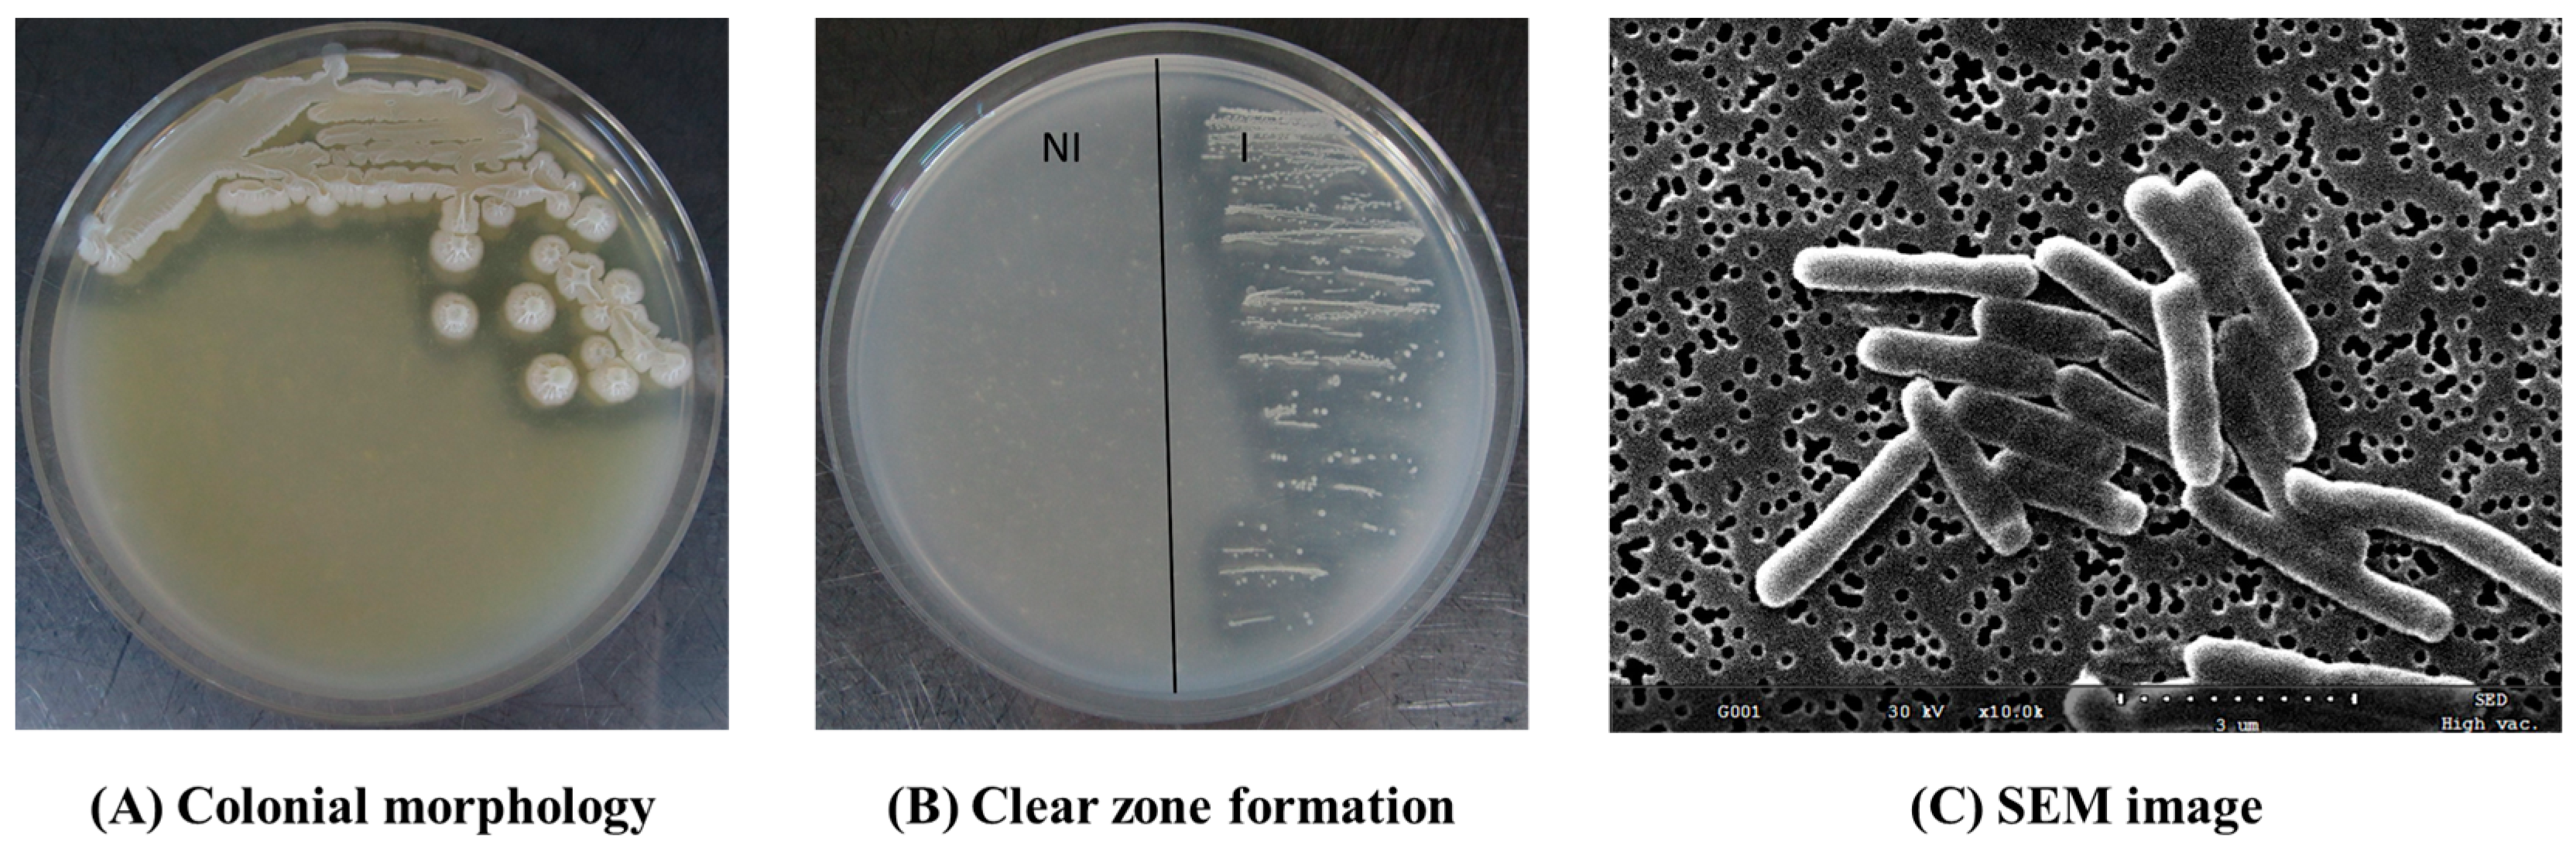
Microorganisms 11 02884 g001

Identification and Growth Characteristics of a Gluten-Degrading Bacterium from Wheat Grains for Gluten-Degrading Enzyme Production
Abstract
:1. Introduction
2. Materials and Methods
2.1. Isolation of Gluten-Degrading Bacterium
2.2. Morphological Observation of Gluten-Degrading Bacteria Using a Scanning Electron Microscope
2.3. Identification of Gluten-Degrading Bacterium
2.4. Examination of the Culture Condition for Gluten-Degrading Enzyme Production
2.5. Biofilm Formation of Gluten-Degrading Bacterium
2.6. Analysis of Bacterial Carbohydrate Fermentation and Enzyme Activity
2.7. Analysis of Decomposition Patterns of Gluten Proteins
2.8. Western Blot Analysis
2.9. Measurement of Crude Enzyme Activity at Different pH
2.10. Statistical Analysis
3. Results and Discussions
3.1. Isolation and Morphological Analysis of the Gluten-Degrading Bacterium
3.2. Species Identification of the Bacterium
3.3. Culture Conditions for Gluten-Degrading Enzyme Production
3.4. Bacterial Carbohydrate Fermentation and Enzyme Activity
3.5. Decomposition Patterns of Gluten Proteins
3.6. The Presence of Immunogenic Protein
3.7. pH Range for Crude Enzyme Activation and the Effect of Gluten Protein Additions on the Enzyme Activity
4. Conclusions
Author Contributions
Funding
Data Availability Statement
Conflicts of Interest
References
- Bradauskiene, V.; Vaiciulyte-Funk, L.; Martinaitiene, D.; Andruskiene, J.; Verma, A.K.; Lima, J.P.; Serin, Y.; Catassi, C. Wheat consumption and prevalence of celiac disease: Correlation from a multilevel analysis. Crit. Rev. Food Sci. Nutr. 2023, 63, 18–32. [Google Scholar] [CrossRef] [PubMed]
- Kõiv, V.; Tenson, T. Gluten-degrading bacteria: Availability and applications. Appl. Microbiol. Biotechnol. 2021, 105, 3045–3059. [Google Scholar] [CrossRef] [PubMed]
- Kumar, B.M.; Sarabhai, S.; Prabhasankar, P. Targeted degradation of gluten proteins in wheat flour by prolyl endoprotease and its utilization in low immunogenic pasta for gluten sensitivity population. J. Cereal Sci. 2019, 87, 59–67. [Google Scholar] [CrossRef]
- Li, Y.; Shi, R.; Qin, C.; Zhang, Y.; Liu, L.; Wu, Z. Gluten-free and prebiotic oat bread: Optimization formulation by transglutaminase improvement dough structure. J. Food Process. Preserv. 2021, 45, e15684. [Google Scholar] [CrossRef]
- Helmerhorst, E.J.; Zamakhchari, M.; Schuppan, D.; Oppenheim, F.G. Discovery of a novel and rich source of gluten-degrading microbial enzymes in the oral cavity. PLoS ONE 2010, 5, e13264. [Google Scholar] [CrossRef] [PubMed]
- Moreno Amador, M.D.L.; Arevalo-Rodriguez, M.; Durán, E.M.; Martinez Reyes, J.C.; Sousa Martin, C. A new microbial gluten-degrading prolyl endopeptidase: Potential application in celiac disease to reduce gluten immunogenic peptides. PLoS ONE 2019, 14, e0218346. [Google Scholar] [CrossRef]
- Hausch, F.; Shan, L.; Santiago, N.A.; Gray, G.M.; Khosla, C. Intestinal digestive resistance of immunodominant gliadin peptides. Am. J. Physiol.-Gastrointest. Liver Physiol. 2002, 283, G996–G1003. [Google Scholar] [CrossRef]
- Wei, G.; Tian, N.; Siezen, R.; Schuppan, D.; Helmerhorst, E.J. Identification of food-grade subtilisins as gluten-degrading enzymes to treat celiac disease. Am. J. Physiol.-Gastrointest. Liver Physiol. 2016, 311, G571–G580. [Google Scholar] [CrossRef]
- Balakireva, A.V.; Zamyatnin, A.A., Jr. Properties of gluten intolerance: Gluten structure, evolution, pathogenicity and detoxification capabilities. Nutrients 2016, 8, 644. [Google Scholar] [CrossRef]
- Fernandez-Feo, M.; Wei, G.; Blumenkranz, G.; Dewhirst, F.E.; Sc8huppan, D.; Oppenheim, F.G.; Helmerhorst, E.J. The cultivable human oral gluten-degrading microbiome and its potential implications in coeliac disease and gluten sensitivity. Clin. Microbiol. Infect. 2013, 19, E386–E394. [Google Scholar] [CrossRef]
- Dewala, S.; Bodkhe, R.; Nimonkar, Y.; Prakash, O.M.; Ahuja, V.; Makharia, G.K.; Shouche, Y.S. Human small-intestinal gluten-degrading bacteria and its potential implication in celiac disease. J. Biosci. 2023, 48, 18. [Google Scholar] [CrossRef]
- Wei, G.; Helmerhorst, E.J.; Darwish, G.; Blumenkranz, G.; Schuppan, D. Gluten degrading enzymes for treatment of celiac disease. Nutrients 2020, 12, 2095. [Google Scholar] [CrossRef]
- Bethune, M.T.; Strop, P.; Tang, Y.; Sollid, L.M.; Khosla, C. Heterologous expression, purification, refolding, and structural-functional characterization of EP-B2, a self-activating barley cysteine endoprotease. Chem. Biol. 2006, 13, 637–647. [Google Scholar] [CrossRef] [PubMed]
- Edens, L.; Dekker, P.; Van Der Hoeven, R.; Deen, F.; de Roos, A.; Floris, R. Extracellular prolyl endoprotease from Aspergillus niger and its use in the debittering of protein hydrolysates. J. Agric. Food Chem. 2005, 53, 7950–7957. [Google Scholar] [CrossRef] [PubMed]
- Choi, J.M.; Han, S.S.; Kim, H.S. Industrial applications of enzyme biocatalysis: Current status and future aspects. Biotechnol. Adv. 2015, 33, 1443–1454. [Google Scholar] [CrossRef] [PubMed]
- Kõiv, V.; Adamberg, K.; Adamberg, S.; Sumeri, I.; Kasvandik, S.; Kisand, V.; Maiväli, Ü.; Tenson, T. Microbiome of root vegetables—A source of gluten-degrading bacteria. Appl. Microbiol. Biotechnol. 2020, 104, 8871–8885. [Google Scholar] [CrossRef] [PubMed]
- Rashmi, B.S.; Gayathri, D.; Vasudha, M.; Prashantkumar, C.S.; Swamy, C.T.; Sunil, K.S.; Somaraja, P.K.; Prakash, P. Gluten hydrolyzing activity of Bacillus spp isolated from sourdough. Microb. Cell Fact. 2020, 19, 130. [Google Scholar] [CrossRef]
- Shan, L.; Marti, T.; Sollid, L.M.; Gray, G.M.; Khosla, C. Comparative biochemical analysis of three bacterial prolyl endopeptidases: Implications for coeliac sprue. Biochem. J. 2004, 383, 311–318. [Google Scholar] [CrossRef]
- Sakandar, H.A.; Usman, K.; Imran, M. Isolation and characterization of gluten-degrading Enterococcus mundtii and Wickerhamomyces anomalus, potential probiotic strains from indigenously fermented sourdough (Khamir). LWT 2018, 91, 271–277. [Google Scholar] [CrossRef]
- Yoon, J.H.; Lee, S.T.; Park, Y.H. Inter-and intraspecific phylogenetic analysis of the genus Nocardioides and related taxa based on 16S rDNA sequences. Int. J. Syst. Evol. Microbiol. 1998, 48, 187–194. [Google Scholar] [CrossRef]
- Saitou, N.; Nei, M. The neighbor-joining method: A new method for reconstructing phylogenetic trees. Mol. Biol. Evol. 1987, 4, 406–425. [Google Scholar] [CrossRef]
- Kumar, S.; Stecher, G.; Li, M.; Knyaz, C.; Tamura, K. MEGA X: Molecular evolutionary genetics analysis across computing platforms. Mol. Biol. Evol. 2018, 35, 1547. [Google Scholar] [CrossRef]
- Jun, J.Y.; Jung, M.J.; Jeong, I.H.; Yamazaki, K.; Kawai, Y.; Kim, B.M. Antimicrobial and antibiofilm activities of sulfated polysaccharides from marine algae against dental plaque bacteria. Mar. Drugs 2018, 16, 301. [Google Scholar] [CrossRef]
- Jun, J.Y.; Nakajima, S.; Yamazaki, K.; Kawai, Y.; Yasui, H.; Konishi, Y. Isolation of antimicrobial agent from the marine algae Cystoseira hakodatensi. Int. J. Food Sci. Technol. 2015, 50, 871–877. [Google Scholar] [CrossRef]
- O’Toole, G.A. Microtiter dish biofilm formation assay. JoVE (J. Vis. Exp.) 2011, 47, 2437. [Google Scholar] [CrossRef]
- Qiao, J.Q.; Wu, H.J.; Huo, R.; Gao, X.W.; Borriss, R. Stimulation of plant growth and biocontrol by Bacillus amyloliquefaciens subsp. plantarum FZB42 engineered for improved action. Chem. Biol. Technol. Agric. 2014, 1, 12. [Google Scholar] [CrossRef]
- WoldemariamYohannes, K.; Wan, Z.; Yu, Q.; Li, H.; Wei, X.; Liu, Y.; Wang, J.; Sun, B. Prebiotic, probiotic, antimicrobial, and functional food applications of Bacillus amyloliquefaciens. J. Agric. Food Chem. 2020, 68, 14709–14727. [Google Scholar] [CrossRef] [PubMed]
- Liu, N.; Ruan, H.; Liu, L.; Zhang, W.; Xu, J. Temperature-induced mutagenesis-based adaptive evolution of Bacillus amyloliquefaciens for improving the production efficiency of menaquinone-7 from starch. J. Chem. Technol. Biotechnol. 2021, 96, 1040–1048. [Google Scholar] [CrossRef]
- Ding, Z.; Ai, L.; Ouyang, A.; Ding, M.; Wang, W.; Wang, B.; Liu, S.; Gu, Z.; Zhang, L.; Shi, G. A two-stage oxygen supply control strategy for enhancing milk-clotting enzyme production by Bacillus amyloliquefaciens. Eur. Food Res. Technol. 2012, 234, 1043–1048. [Google Scholar] [CrossRef]
- Toyofuku, M.; Inaba, T.; Kiyokawa, T.; Obana, N.; Yawata, Y.; Nomura, N. Environmental factors that shape biofilm formation. Biosci. Biotechnol. Biochem. 2016, 80, 7–12. [Google Scholar] [CrossRef]
- Cai, G.; Wu, D.; Li, X.; Lu, J. Levan from Bacillus amyloliquefaciens JN4 acts as a prebiotic for enhancing the intestinal adhesion capacity of Lactobacillus reuteri JN101. Int. J. Biol. Macromol. 2020, 146, 482–487. [Google Scholar] [CrossRef]
- Dunaevsky, Y.E.; Tereshchenkova, V.F.; Belozersky, M.A.; Filippova, I.Y.; Oppert, B.; Elpidina, E.N. Effective degradation of gluten and its fragments by gluten-specific peptidases: A review on application for the treatment of patients with gluten sensitivity. Pharmaceutics 2021, 13, 1603. [Google Scholar] [CrossRef] [PubMed]
- Méndez, P.X.; Uña, J.A.; Vega-Fernández, S.; Santos, M.Á. The ability of the yeast Wickerhamomyces anomalus to hydrolyze immunogenic wheat gliadin proteins. Foods 2022, 11, 4105. [Google Scholar] [CrossRef] [PubMed]
- Lammers, K.M.; Herrera, M.G.; Dodero, V.I. Translational Chemistry Meets Gluten-Related Disorders. Chem. Open 2008, 7, 217–232. [Google Scholar] [CrossRef] [PubMed]
- Woldemariam, K.Y.; Yuan, J.; Wan, Z.; Yu, Q.; Cao, Y.; Mao, H.; Liu, Y.; Wang, J.; Li, H.; Sun, B. Celiac disease and immunogenic wheat gluten peptides and the association of gliadin peptides with HLA DQ2 and HLA DQ8. Food Rev. Int. 2022, 38, 1553–1576. [Google Scholar] [CrossRef]
- Herrán, A.R.; Pérez-Andrés, J.; Caminero, A.; Nistal, E.; Vivas, S.; de Morales, J.M.R.; Casqueiro, J. Gluten-degrading bacteria are present in the human small intestine of healthy volunteers and celiac patients. Res. Microbiol. 2007, 168, 673–684. [Google Scholar] [CrossRef]

Disclaimer/Publisher’s Note: The statements, opinions and data contained in all publications are solely those of the individual author(s) and contributor(s) and not of MDPI and/or the editor(s). MDPI and/or the editor(s) disclaim responsibility for any injury to people or property resulting from any ideas, methods, instructions or products referred to in the content. |
© 2023 by the authors. Licensee MDPI, Basel, Switzerland. This article is an open access article distributed under the terms and conditions of the Creative Commons Attribution (CC BY) license (https://creativecommons.org/licenses/by/4.0/).
Share and Cite
Lee, G.-Y.; Jung, M.-J.; Kim, B.-M.; Jun, J.-Y. Identification and Growth Characteristics of a Gluten-Degrading Bacterium from Wheat Grains for Gluten-Degrading Enzyme Production. Microorganisms 2023, 11, 2884. https://doi.org/10.3390/microorganisms11122884
Lee G-Y, Jung M-J, Kim B-M, Jun J-Y. Identification and Growth Characteristics of a Gluten-Degrading Bacterium from Wheat Grains for Gluten-Degrading Enzyme Production. Microorganisms. 2023; 11(12):2884. https://doi.org/10.3390/microorganisms11122884
Chicago/Turabian StyleLee, Ga-Yang, Min-Jeong Jung, Byoung-Mok Kim, and Joon-Young Jun. 2023. "Identification and Growth Characteristics of a Gluten-Degrading Bacterium from Wheat Grains for Gluten-Degrading Enzyme Production" Microorganisms 11, no. 12: 2884. https://doi.org/10.3390/microorganisms11122884
APA StyleLee, G.-Y., Jung, M.-J., Kim, B.-M., & Jun, J.-Y. (2023). Identification and Growth Characteristics of a Gluten-Degrading Bacterium from Wheat Grains for Gluten-Degrading Enzyme Production. Microorganisms, 11(12), 2884. https://doi.org/10.3390/microorganisms11122884

